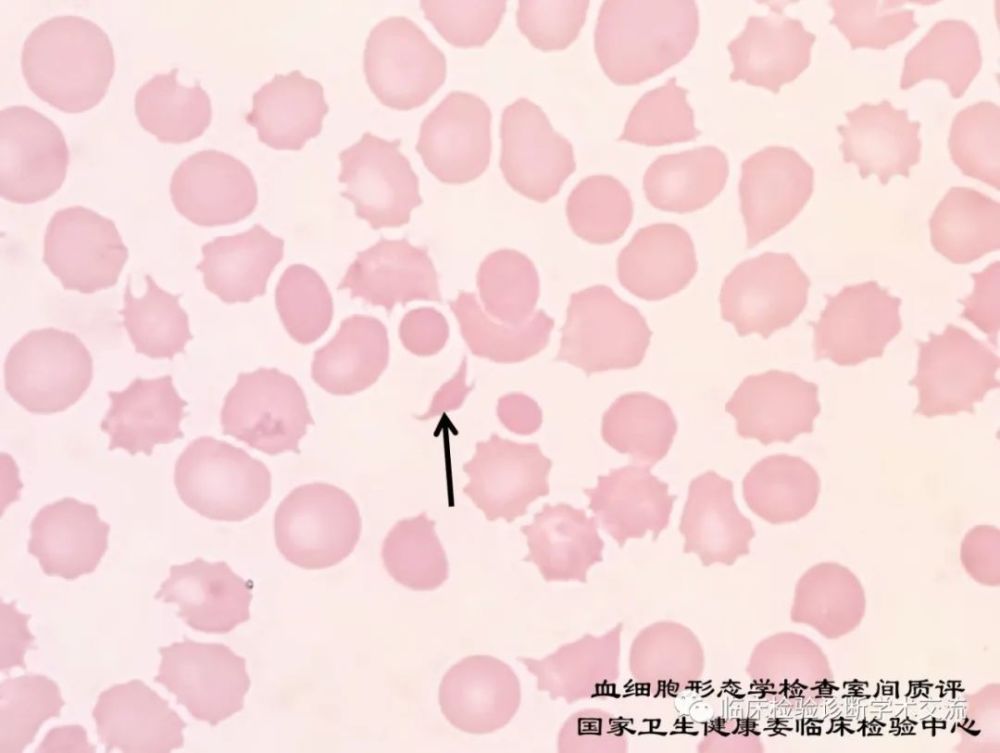
卫健委临检中心2020年血细胞形态学检查室间质量评价及答案

临检形态学图片

卫健委临检中心2020年血细胞形态学检查室间质量评价及答案
图片尺寸1000x753
卫健委临检中心2020年血细胞形态学检查室间质量评价及答案
图片尺寸1000x753
2019年第2次福建省临床实验室形态学检查室间质评图谱血细胞形态学
图片尺寸900x720
临床体液及排泄物形态学检查图谱第2版典型形态学图片助你练就火眼金
图片尺寸704x900
秀山县医学检验质量控制中心第17次形态学培训答案
图片尺寸1200x1064
卫健委临检中心2020年血细胞形态学检查室间质量评价及答案
图片尺寸1000x753
卫健委临检中心2020年血细胞形态学检查室间质量评价及答案
图片尺寸650x474
记一次有意义的临床细胞形态学实践
图片尺寸854x640
2019年尿液沉渣形态学检查室间质控评价
图片尺寸1000x892
卫健委临检中心2020年血细胞形态学检查室间质量评价及答案
图片尺寸650x474
第61期重庆市检验质控中心"金显微镜"形态学培训—璧山区检验质控中心
图片尺寸1199x1199
记一次有意义的临床细胞形态学实践
图片尺寸854x640
卫健委临检中心2020年血细胞形态学检查室间质量评价及答案
图片尺寸1000x753
记一次有意义的临床细胞形态学实践
图片尺寸854x640
秀山医学检验质量控制中心第二十六期形态学培训答案解析
图片尺寸904x976临检检验科血细胞形态
图片尺寸1080x821
卫健委临检中心2020年血细胞形态学检查室间质量评价及答案
图片尺寸1000x753
秀山医学检验质量控制中心第二十六期形态学培训答案解析
图片尺寸1065x1287
国家卫健委临检中心2019年第3次血细胞形态学检查室间质量评价及答案
图片尺寸660x497
第61期重庆市检验质控中心"金显微镜"形态学培训—璧山区检验质控中心
图片尺寸1241x1151
猜你喜欢:细胞形态学图片及答案临床检验形态图片大全尿液形态学图片及名字细胞形态学图谱及答案血细胞形态学图片检验形态学细胞形态学图谱体液形态学图谱病理形态学绘图尿液形态学图谱2020尿沉渣形态学图片尿液形态学图片及答案尿沉渣形态学图谱形态学绘图血液细胞形态学图谱骨髓细胞形态学检查形态学骨髓细胞形态学图谱细胞形态学2019尿沉渣形态学图片寄生虫形态学图谱形态学绘图大赛骨髓细胞形态学人体形态学人体形态学实验人体形态学结构绘图动物形态学人体形态学绘图作品人体形态学绘图大赛股票形态学桃子图片卡通 可爱结婚妈妈发型马嘉祺量婚纱兔八哥历险记游戏婚礼全家福照片配文深圳酒吧驻唱歌手彩铅画长颈鹿朱熹书法碑帖绿色潮图壁纸 抖音宇智波反弹gif小米a8手机安徽定远特产小吃